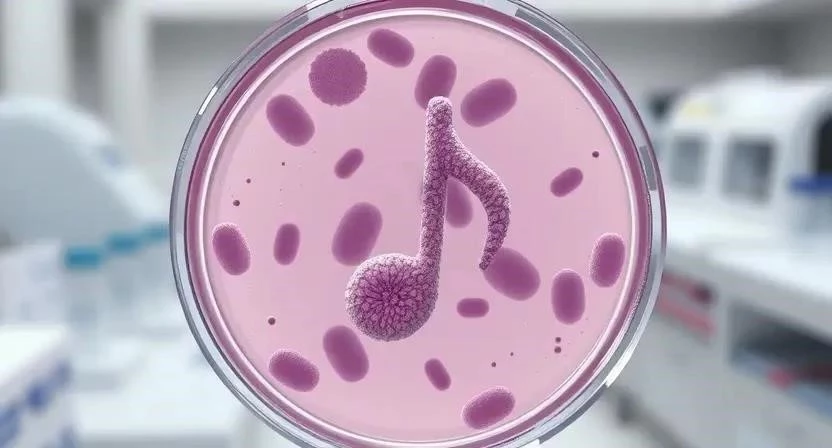

Задумывались ли вы когда-нибудь, что может объединять микроскопические вирусы и величественное искусство? На первый взгляд, связь кажется невероятной. Однако, последние исследования показывают, что между этими двумя, казалось бы, далекими областями существует удивительная взаимосвязь. Вирусы, как известно, постоянно мутируют и адаптируются, а искусство, в свою очередь, является мощным инструментом адаптации и выражения человеческой психики. Ключевое слово – вирусные инфекции. Эта статья исследует эту захватывающую связь, раскрывая, как творчество может влиять на наше здоровье и даже на эволюцию вирусов.
Вирусы и их эволюция
Вирусы – это микроскопические инфекционные агенты, которые размножаются только внутри живых клеток. Их строение относительно простое: генетический материал (ДНК или РНК), заключенный в белковую оболочку. Классификация вирусов основана на типе генетического материала, форме и способе передачи. Мутации – это изменения в генетическом коде вируса, которые могут происходить спонтанно или под воздействием внешних факторов. Эволюция вирусов – это процесс, посредством которого они адаптируются к новым условиям, приобретая устойчивость к препаратам и способность заражать новые виды организмов. Я помню, как в детстве болел гриппом каждый год, и каждый раз болезнь протекала по-разному. Это, наверное, и есть результат вирусной эволюции.
| Класс вирусов | Тип генетического материала | Примеры | Основные характеристики |
|---|---|---|---|
| ДНК-вирусы | Двуцепочечная ДНК | Вирус герпеса, вирус оспы | Относительно стабильны, часто вызывают хронические инфекции |
| РНК-вирусы | Одноцепочечная РНК | Вирус гриппа, вирус кори | Высокая скорость мутаций, часто вызывают эпидемии |
| Ретровирусы | Одноцепочечная РНК с обратной транскриптазой | ВИЧ | Интегрируются в геном клетки-хозяина, вызывают хронические инфекции |
| Двуцепочечная РНК | Двуцепочечная РНК | Вирус рота | Высокая скорость репликации, часто вызывают острые инфекции |
Искусство как терапия
Целительная сила искусства известна с древних времен. Арт-терапия – это форма психотерапии, которая использует творческие методы для улучшения психического и эмоционального состояния человека. Исследования Всемирной организации здравоохранения (ВОЗ) подтверждают эффективность арт-терапии при лечении различных неинфекционных заболеваний, таких как депрессия, тревожные расстройства и посттравматический стрессовый синдром. Однажды я видел, как мой друг, переживший тяжелую утрату, нашел утешение в живописи. Это было невероятно.
Религия и вирус
Существует необычная теория, предполагающая, что религия может быть своего рода «вирусом мозга». Эта концепция предполагает, что религиозные идеи распространяются подобно вирусам, заражая умы людей и влияя на их поведение. Адаптация и эволюция играют ключевую роль в этой теории, поскольку религиозные верования могут способствовать выживанию и размножению людей. Культурное влияние религии огромно, и оно может оказывать как положительное, так и отрицательное воздействие на общество. Я всегда интересовался, почему религия так глубоко укоренена в человеческой культуре.

Влияние искусства на психику
Искусство оказывает глубокое влияние на психические процессы. Оно способно вызывать эмоции, стимулировать воображение и расширять сознание. Адаптивные свойства психики позволяют нам справляться со стрессом и адаптироваться к изменяющимся условиям. Связь искусства с другими аспектами культуры, такими как музыка, литература и театр, делает его неотъемлемой частью человеческого опыта. Я заметил, что когда я слушаю музыку, я чувствую себя более спокойным и сосредоточенным.
Вирусные инфекции и иммунитет
Вирусы обладают удивительной способностью вырабатывать иммунитет к препаратам, что затрудняет борьбу с инфекциями. Поиск новых противовирусных средств – это постоянная задача для ученых. Недавно я читал статью о разработке нового препарата против ВИЧ. Это вселяет надежду.
Искусство и иммунная система
Возможна ли связь между творчеством и укреплением иммунной системы? Некоторые исследования показывают, что творческая деятельность может снижать уровень стресса, что, в свою очередь, положительно влияет на иммунную функцию. Психологическое воздействие искусства может способствовать выработке эндорфинов, которые обладают иммуномодулирующими свойствами. Я думаю, что когда мы занимаемся тем, что нам нравится, наш организм чувствует себя лучше.
| Аспект здоровья | Влияние искусства | Механизм воздействия |
|---|---|---|
| Психическое здоровье | Снижение стресса, улучшение настроения | Выработка эндорфинов, стимуляция творческого мышления |
| Физическое здоровье | Укрепление иммунной системы | Снижение уровня кортизола, улучшение кровообращения |
| Эмоциональное здоровье | Выражение эмоций, развитие эмпатии | Катарсис, самопознание |
Мифы и заблуждения
Существует множество мифов и заблуждений о вирусах и искусстве. Например, некоторые люди считают, что вирусы – это всегда зло, в то время как другие преувеличивают целительную силу искусства. Научное объяснение этих явлений позволяет нам более объективно оценивать их влияние на нашу жизнь. Я часто слышу, что искусство – это только для избранных. Это неправда!
FAQ
- Что такое арт-терапия? Арт-терапия – это форма психотерапии, которая использует творческие методы для улучшения психического и эмоционального состояния человека.
- Как вирусы эволюционируют? Вирусы эволюционируют посредством мутаций, которые позволяют им адаптироваться к новым условиям и приобретать устойчивость к препаратам.
- Может ли искусство укрепить иммунную систему? Некоторые исследования показывают, что творческая деятельность может снижать уровень стресса, что положительно влияет на иммунную функцию.
- Что такое теория о религии как вирусе мозга? Эта теория предполагает, что религиозные идеи распространяются подобно вирусам, заражая умы людей и влияя на их поведение.
- Какие существуют противовирусные препараты? Существует множество противовирусных препаратов, которые используются для лечения различных вирусных инфекций.
- Как часто нужно заниматься творчеством для улучшения здоровья? Регулярные занятия творчеством, даже небольшие, могут оказать положительное влияние на ваше здоровье.
- В чем разница между ДНК и РНК вирусами? ДНК-вирусы содержат ДНК в качестве генетического материала, а РНК-вирусы содержат РНК. РНК-вирусы обычно мутируют быстрее.
| Проблема | Причина | Решение |
|---|---|---|
| Вирусная устойчивость к препаратам | Мутации вируса | Разработка новых противовирусных средств |
| Стресс и снижение иммунитета | Хроническое напряжение | Арт-терапия, медитация, физические упражнения |
| Негативное влияние религиозного фанатизма | Нетерпимость, экстремизм | Образование, толерантность, диалог |
| Миф/Примета | Объяснение | Научный факт |
|---|---|---|
| Вирусы – это всегда зло | Вирусы могут быть полезны для эволюции и иммунной системы | Некоторые вирусы используются в генной терапии |
| Искусство – это только для избранных | Творчество доступно каждому | Арт-терапия помогает людям с различными потребностями |
| Религия – это всегда хорошо | Религия может быть источником конфликтов и насилия | Религиозный фанатизм может приводить к экстремизму |







